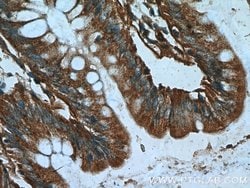
DTX1 Rabbit anti-Human, Mouse, Rat, Polyclonal, Proteintech 20 &mu;L; Unconjugated:Antibodies,

missing translation for 'onlineSavingsMsg'
Learn More
Learn More
DTX1 Rabbit anti-Human, Mouse, Rat, Polyclonal, Proteintech
Rabbit Polyclonal Antibody
Brand: Proteintech 18350-1-AP-20UL
This item is not returnable.
View return policy
Description
This antibody recognizes DTX1 protein (72 kDa) and it's isoforms (about 60 kDa).
Studies in Drosophila have identified this gene as encoding a positive regulator of the Notch-signaling pathway. The human gene encodes a protein of unknown function; however, it may play a role in basic helix-loop-helix transcription factor activity.Specifications
| DTX1 | |
| Polyclonal | |
| Unconjugated | |
| DTX1 | |
| deltex homolog 1 (Drosophila), Deltex1, DTX1, hDTX1, hDx 1, Protein deltex 1 | |
| Rabbit | |
| Antigen Affinity Chromatography | |
| RUO | |
| 14357, 1840, 687424 | |
| -20°C | |
| Liquid |
| Immunohistochemistry (Paraffin), Immunocytochemistry, Immunofluorescence, Immunohistochemistry (Frozen) | |
| 0.23 mg/mL | |
| PBS with 50% glycerol and 0.1% sodium azide; pH 7.3 | |
| Q61010, Q86Y01 | |
| DTX1 | |
| DTX1 Fusion Protein Ag13172 | |
| 20 μL | |
| Primary | |
| Mouse, Rat, Human | |
| Antibody | |
| IgG |
Product Content Correction
Your input is important to us. Please complete this form to provide feedback related to the content on this product.
Product Title
Spot an opportunity for improvement?Share a Content Correction